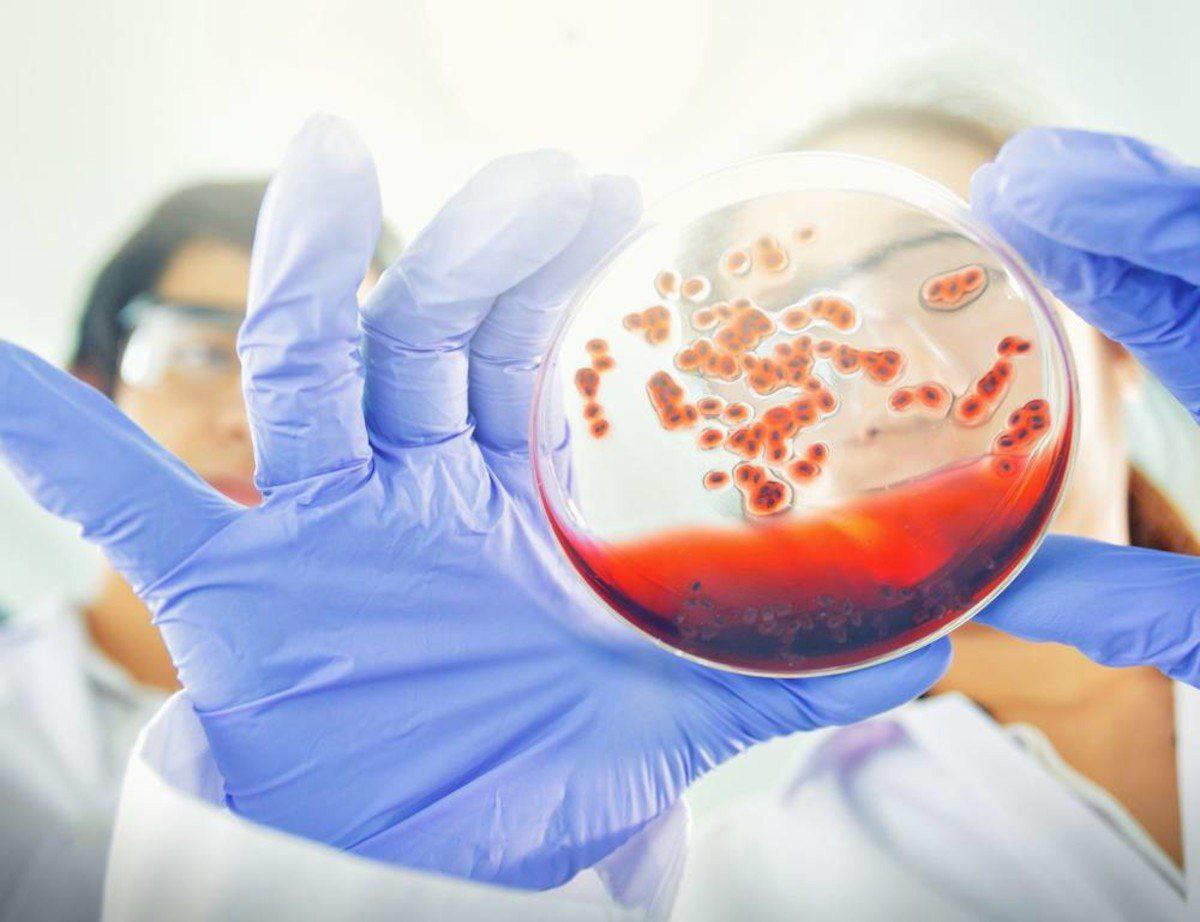

Самые заразные болезни
Мебели г шахты
Червонец 1980 пруф
Kimeros park holiday village турция кемер
Мониторинг деструктивных проявлений
Расписание автобусов кемерово 21
Ночные кормления в 4 месяца
Что нужно для рефинансирования кредита
Разъяренный крик
Где можно снять беседку для шашлыка
Аспекты терроризма и экстремизма
Личностное образование в психологии
Погода хмао карымкары октябрьский
Ламинат красивый пол
Самые заразные болезни 134 фотографий